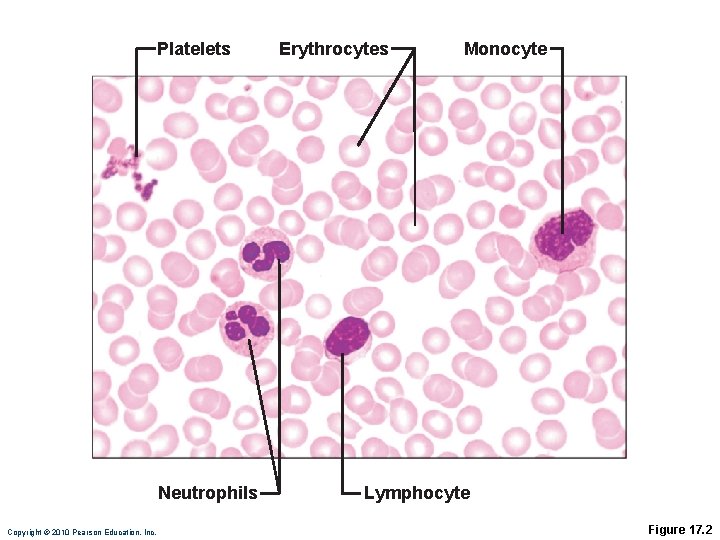
Platelets Neutrophils Copyright © 2010 Pearson Education, Inc. Erythrocytes Monocyte Lymphocyte Figure 17. 2

Copyright 2010 Pearson Education Inc Copyright 2010 Pearson

- Slides: 88
Copyright © 2010 Pearson Education, Inc.
Copyright © 2010 Pearson Education, Inc.
Copyright © 2010 Pearson Education, Inc.
Copyright © 2010 Pearson Education, Inc. Figure 17. 1
Physical Characteristics and Volume • Color scarlet to dark red • p. H 7. 35– 7. 45 • 38 C • ~8% of body weight • Ave vol: 5– 6 L for males, 4– 5 L for females Copyright © 2010 Pearson Education, Inc.
Copyright © 2010 Pearson Education, Inc.
Table 17. 1 Composition of Plasma (1 of 2) Copyright © 2010 Pearson Education, Inc.
Table 17. 1 Composition of Plasma (2 of 2) Copyright © 2010 Pearson Education, Inc.
Platelets Neutrophils Copyright © 2010 Pearson Education, Inc. Erythrocytes Monocyte Lymphocyte Figure 17. 2
Erythrocytes • Biconcave discs, anucleate, organelles • Spectrin protein for flexibility • Major factor contributing to blood viscosity • Biconcave shape—huge surface area relative to volume • >97% hemoglobin • No mitochondria; ATP produced anaerobic Copyright © 2010 Pearson Education, Inc.
2. 5 µm Side view (cut) 7. 5 µm Top view Copyright © 2010 Pearson Education, Inc. Figure 17. 3
b Globin chains Heme group a Globin chains (a) Hemoglobin consists of globin (two alpha and two beta polypeptide chains) and four heme groups. Copyright © 2010 Pearson Education, Inc. (b) Iron-containing heme pigment. Figure 17. 4
Hemoglobin (Hb) • O 2 loading produces oxyhemoglobin • O 2 unloading produces deoxyhemoglobin or reduced hemoglobin (dark red) • CO 2 loading produces carbaminohemoglobin (carries 20% of CO 2) Copyright © 2010 Pearson Education, Inc.
Hemoglobin (Hb) • O 2 loading in lungs • Produces oxyhemoglobin (ruby red) • O 2 unloading in tissues • Produces deoxyhemoglobin (dark red) • CO 2 loading in tissues • 20% of CO 2 in blood binds to Hb carbaminohemoglobin © 2013 Pearson Education, Inc. Copyright © 2010 Pearson Education, Inc.
Hematopoiesis • Hematopoiesis (hemopoiesis): RBC formation • Occurs in red marrow of axial skeleton, girdles and proximal epiphyses of humerus and femur Copyright © 2010 Pearson Education, Inc.
Stem cell Hemocytoblast Copyright © 2010 Pearson Education, Inc. Committed cell Developmental pathway Proerythroblast Early Late erythroblast Phase 1 Ribosome synthesis Phase 2 Hemoglobin accumulation Phase 3 Ejection of nucleus Normoblast Reticulo- Erythrocyte Figure 17. 5
Hormonal Control of Erythropoiesis • Erythropoietin (EPO) • Direct stimulus for erythropoiesis • Released by kidneys in response Copyright © 2010 Pearson Education, Inc.
Hormonal Control of Erythropoiesis • Causes of hypoxia • Hemorrhage or increased RBC destruction • Insufficient hemoglobin (e. g. , iron deficiency) • Reduced availability of O 2 (e. g. , high altitudes) Copyright © 2010 Pearson Education, Inc.
Hormonal Control of Erythropoiesis • Effects of EPO • Maturation of committed RBCs • Increased reticulocyte count in 1– 2 d • Testosterone also enhances EPO production, resulting in higher RBC counts in males Copyright © 2010 Pearson Education, Inc.
Copyright © 2010 Pearson Education, Inc.
Slide 1 IMB AL AN CE Homeostasis: Normal blood oxygen levels IMB 5 O 2 -carrying ability of blood rises. AL 4 Enhanced erythropoiesis increases RBC count. 3 Erythropoietin stimulates red bone marrow. © 2013 Pearson Education, Inc. Copyright © 2010 Pearson Education, Inc. AN CE 1 Stimulus: Hypoxia (inadequate O 2 delivery) due to • Decreased RBC count • Decreased amount of hemoglobin • Decreased availability of O 2 2 Kidney (and liver to a smaller extent) releases erythropoietin.
Dietary Requirements for Erythropoiesis • Nutrients—amino acids, lipids, and carbs • Iron • Stored in Hb (65%), liver, spleen, bone marrow • Stored in cells as ferritin and hemosiderin • Transported bound to transferrin • Vit B 12 and folic acid—necessary for DNA synthesis for cell division Copyright © 2010 Pearson Education, Inc.
1 Low O 2 levels in blood stimulate kidneys to produce erythropoietin. Copyright © 2010 Pearson Education, Inc. Figure 17. 7, step 1
1 Low O 2 levels in blood stimulate kidneys to produce erythropoietin. 2 Erythropoietin levels rise in blood. Copyright © 2010 Pearson Education, Inc. Figure 17. 7, step 2
1 Low O 2 levels in blood stimulate kidneys to produce erythropoietin. 2 Erythropoietin levels rise in blood. 3 Erythropoietin and necessary raw materials in blood promote erythropoiesis in red bone marrow. Copyright © 2010 Pearson Education, Inc. Figure 17. 7, step 3
1 Low O 2 levels in blood stimulate kidneys to produce erythropoietin. 2 Erythropoietin levels rise in blood. 3 Erythropoietin and necessary raw materials in blood promote erythropoiesis in red bone marrow. 4 New erythrocytes enter bloodstream; function about 120 days. Copyright © 2010 Pearson Education, Inc. Figure 17. 7, step 4
5 Aged and damaged red blood cells are engulfed by macrophages of liver, spleen, and bone marrow; the Bilirubin hemoglobin is broken down. Hemoglobin Heme Globin Amino Iron stored acids as ferritin, hemosiderin Bilirubin is picked up from blood by liver, secreted into intestine in bile, metabolized to stercobilin by bacteria, and excreted in feces. Circulation Copyright © 2010 Pearson Education, Inc. Figure 17. 7, step 5
5 Aged and damaged red blood cells are engulfed by macrophages of liver, spleen, and bone marrow; the Bilirubin hemoglobin is broken down. Hemoglobin Heme Globin Amino Iron stored acids as ferritin, hemosiderin Iron is bound to transferrin and released to blood from liver as needed for erythropoiesis. Bilirubin is picked up from blood by liver, secreted into intestine in bile, metabolized to stercobilin by bacteria, and excreted in feces. Circulation Food nutrients, including amino acids, Fe, B 12, and folic acid, are absorbed from intestine and enter blood. Copyright © 2010 Pearson Education, Inc. 6 Raw materials are made available in blood for erythrocyte synthesis. Figure 17. 7, step 6
Erythrocyte Disorders • Anemia: low O 2 -carrying capacity • A sign rather than a disease itself • Blood O 2 levels cannot support normal metabolism • Accompanied by fatigue, paleness, shortness of breath, and chills Copyright © 2010 Pearson Education, Inc.
Causes of Anemia 1. Insufficient erythrocytes • Hemorrhagic anemia: acute or chronic loss of blood • Hemolytic anemia: RBCs rupture prematurely • Aplastic anemia: destruction or inhibition of red bone marrow Copyright © 2010 Pearson Education, Inc.
Causes of Anemia 2. Low hemoglobin content • Iron-deficiency anemia • Secondary result of hemorrhagic anemia or • Inadequate intake of iron-containing foods or • Impaired iron absorption Copyright © 2010 Pearson Education, Inc.
Causes of Anemia • Pernicious anemia • Deficiency of vitamin B 12 • Lack of intrinsic factor needed for absorption of B 12 • Treated by intramuscular injection of B 12 or application of Nascobal Copyright © 2010 Pearson Education, Inc.
Causes of Anemia 3. Abnormal hemoglobin • Thalassemias • Absent or faulty globin chain • RBCs are thin, delicate, and deficient in hemoglobin Copyright © 2010 Pearson Education, Inc.
Causes of Anemia • Sickle-cell anemia • Defective gene codes for abnormal hemoglobin (Hb. S) • Causes RBCs to become sickle shaped in low-oxygen situations Copyright © 2010 Pearson Education, Inc.
(a) Normal erythrocyte has normal hemoglobin amino acid sequence in the beta chain. 1 2 3 4 5 6 7 146 (b) Sickled erythrocyte results from a single amino acid change in the beta chain of hemoglobin. 1 2 3 4 5 6 7 146 Copyright © 2010 Pearson Education, Inc. Figure 17. 8
Erythrocyte Disorders • Polycythemia vera • Bone marrow cancer excess RBCs • Severely increased blood viscosity • Secondary polycythemia • Less O 2 available (high altitude) or EPO production increases higher RBC count • Blood doping Copyright © 2010 Pearson Education, Inc.
Leukocytes • Make up <1% of blood volume • 4, 800 – 10, 800 WBCs/μl blood • Function in defense against disease • Can leave capillaries via diapedesis • Move through tissue spaces by ameboid motion and positive chemotaxis • Leukocytosis: WBC count over 11, 000/mm 3 • Normal response to infection Copyright © 2010 Pearson Education, Inc.
Differential WBC count (All total 4800 – 10, 800/l) Formed elements Platelets Leukocytes Granulocytes Neutrophils (50 – 70%) Eosinophils (2 – 4%) Basophils (0. 5 – 1%) Erythrocytes Agranulocytes Lymphocytes (25 – 45%) Monocytes (3 – 8%) Copyright © 2010 Pearson Education, Inc. Figure 17. 9
Copyright © 2010 Pearson Education, Inc.
Granulocytes • Granulocytes: neutrophils, eosinophils, and basophils • Larger and shorter-lived than RBCs • Lobed nuclei • Phagocytic Copyright © 2010 Pearson Education, Inc.
Neutrophils • Most numerous • Granules contain hydrolytic enzymes or defensins • Very phagocytic—“bacteria slayers” Copyright © 2010 Pearson Education, Inc.
Eosinophils • Digest parasitic worms that are too large to be phagocytized • Modulators of immune response Copyright © 2010 Pearson Education, Inc.
Basophils • Rarest WBCs • Release histamine: an inflammatory chemical that acts as a vasodilator and attracts other WBCs to inflamed sites • Are functionally similar to mast cells Copyright © 2010 Pearson Education, Inc.
(a) Neutrophil; multilobed nucleus Copyright © 2010 Pearson Education, Inc. (b) Eosinophil; bilobed nucleus, red cytoplasmic granules (c) Basophil; bilobed nucleus, purplish-black cytoplasmic granules Figure 17. 10 (a-c)
Agranulocytes • Lymphocytes: Two types • T cells act against virus-infected cells and tumor cells • B cells give rise to plasma cells, which produce antibodies Copyright © 2010 Pearson Education, Inc.
Monocytes • Leave circulation, enter tissues, and differentiate into macrophages • Actively phagocytic cells; crucial against viruses, intracellular bacterial parasites, and chronic infections • Activate lymphocytes to mount an immune response Copyright © 2010 Pearson Education, Inc.
(d) Small lymphocyte; large spherical nucleus Copyright © 2010 Pearson Education, Inc. (e) Monocyte; kidney-shaped nucleus Figure 17. 10 d, e
Copyright © 2010 Pearson Education, Inc. Table 17. 2 (1 of 2)
Copyright © 2010 Pearson Education, Inc. Table 17. 2 (2 of 2)
Leukopoiesis • Production of WBCs • Stimulated by 2 types of chemical messengers from red bone marrow and mature WBCs • Interleukins (e. g. , IL-3, IL-5) • Colony-stimulating factors (CSFs) named for WBC type they stimulate (e. g. , granulocyte. CSF stimulates granulocytes) • All leukocytes originate from hemocytoblasts Copyright © 2010 Pearson Education, Inc.
Stem cells Hemocytoblast Lymphoid stem cell Myeloid stem cell Committed cells Developmental pathway Myeloblast Monoblast Lymphoblast Promyelocyte Promonocyte Promyelocyte Eosinophilic myelocyte Basophilic myelocyte Neutrophilic myelocyte Eosinophilic band cells Basophilic band cells Neutrophilic band cells Monocytes Eosinophils Basophils Neutrophils (a) (b) (c) (d) Granular leukocytes Copyright © 2010 Pearson Education, Inc. Prolymphocyte Lymphocytes (e) Agranular leukocytes Some become Figure 17. 11
Leukocyte Disorders • Leukopenia • Abnormally low WBC count—drug induced • Leukemias • Cancerous conditions involving WBCs • Named according to the abnormal WBC clone involved • Myelocytic leukemia involves myeloblasts • Lymphocytic leukemia involves lymphocytes • Acute leukemia primarily affects children • Chronic leukemia is more prevalent in older people Copyright © 2010 Pearson Education, Inc.
Platelets • Cytoplasmic fragments of megakaryocytes • Granules contain serotonin, Ca 2+, enzymes, ADP, and platelet-derived growth factor (PDGF) • Act in clotting process • Normal = 150, 000 – 400, 000 platelets /ml Copyright © 2010 Pearson Education, Inc.
Platelets • Form a temporary platelet plug that helps seal breaks in blood vessels • Circulating platelets are kept inactive and mobile by NO and prostacyclin from endothelial cells of blood vessels • Age quickly; degenerate in about 10 days Copyright © 2010 Pearson Education, Inc.
Stem cell Developmental pathway Hemocytoblast Promegakaryocyte Megakaryoblast Megakaryocyte Copyright © 2010 Pearson Education, Inc. Platelets Figure 17. 12
Hemostasis • Fast series of reactions for stoppage of bleeding 1. Vascular spasm 2. Platelet plug formation 3. Coagulation (blood clotting) Copyright © 2010 Pearson Education, Inc.
Vascular Spasm • Vasoconstriction of damaged blood vessel • Triggers • Direct injury • Chemicals released by endothelial cells and platelets • Pain reflexes Copyright © 2010 Pearson Education, Inc.
Platelet Plug Formation • Positive feedback • At site of blood vessel injury, platelets • Stick to exposed collagen fibers with the help of von Willebrand factor, a plasma protein • Swell, become spiked and sticky, and release chemical messengers • ADP causes more platelets to stick and release their contents • Serotonin and thromboxane A 2 enhance vascular spasm and more platelet aggregation Copyright © 2010 Pearson Education, Inc.
Step 1 Vascular spasm • Smooth muscle contracts, causing vasoconstriction. Collagen fibers Step 2 Platelet plug formation • Injury to lining of vessel exposes collagen fibers; platelets adhere. • Platelets release chemicals that make nearby platelets sticky; platelet plug forms. Platelets Fibrin Copyright © 2010 Pearson Education, Inc. Step 3 Coagulation • Fibrin forms a mesh that traps red blood cells and platelets, forming the clot. Figure 17. 13
Coagulation • Three phases of coagulation 1. Prothrombin formed (intrinsic and extrinsic pathways) 2. Prothrombin is converted into thrombin 3. Thrombin catalyzes fibrinogen into fibrin mesh Copyright © 2010 Pearson Education, Inc.
Phase 1 Intrinsic pathway Vessel endothelium ruptures, exposing underlying tissues (e. g. , collagen) Platelets cling and their surfaces provide sites for mobilization of factors XIIa XI Ca 2+ VIIa Ca 2+ PF 3 released by aggregated platelets Tissue factor (TF) VII XIa IX Extrinsic pathway Tissue cell trauma exposes blood to IXa VIIIa TF/VIIa complex IXa/VIIIa complex X Ca 2+ PF 3 Xa V Va Prothrombin activator Copyright © 2010 Pearson Education, Inc. Figure 17. 14 (1 of 2)
Phase 2 Prothrombin activator Prothrombin (II) Thrombin (IIa) Phase 3 Fibrinogen (I) (soluble) Ca 2+ Fibrin (insoluble polymer) XIIIa Cross-linked fibrin mesh Copyright © 2010 Pearson Education, Inc. Figure 17. 14 (2 of 2)
Coagulation Phase 1: Two Pathways to Prothrombin Activator • Initiated by either the intrinsic or extrinsic pathway (usually both) • Triggered by tissue-damaging events • Involves a series of procoagulants • Each pathway cascades toward factor X • Factor X complexes with Ca 2+, PF 3, and factor V to form prothrombin activator Copyright © 2010 Pearson Education, Inc.
Coagulation Phase 1: Two Pathways to Prothrombin Activator • Intrinsic pathway • Triggered by negatively charged surfaces (activated platelets, collagen, glass) • Uses factors present within blood (intrinsic) • Extrinsic pathway • Triggered by exposure to tissue factor (TF) or factor III (an extrinsic factor) • Bypasses several steps of intrinsic pathway, so faster Copyright © 2010 Pearson Education, Inc.
Common Pathway to the Fibrin Mesh • Thrombin converts soluble fibrinogen into fibrin • Fibrin form clot • Thrombin (with Ca 2+) activates factor XIII which: • Cross-links fibrin • Strengthens and stabilizes clot Copyright © 2010 Pearson Education, Inc.
Copyright © 2010 Pearson Education, Inc. Figure 17. 15
Clot Retraction • Stabilizes clot • Actin and myosin in platelets contract within 30– 60 minutes • Contraction pulls on fibrin strands, squeezing serum from clot • Draws ruptured blood vessel edges together Copyright © 2010 Pearson Education, Inc.
Clot Repair • Platelet-derived growth factor (PDGF) stimulates division of smooth muscle cells and fibroblasts to rebuild blood vessel wall • Vascular endothelial growth factor (VEGF) stimulates endothelial cells to multiply and restore the endothelial lining Copyright © 2010 Pearson Education, Inc.
Fibrinolysis • Removes unneeded clots after healing • Begins within two days; continues for several • Plasminogen in clot is converted to plasmin by tissue plasminogen activator (t. PA), factor XII and thrombin • Plasmin is a fibrin-digesting enzyme Copyright © 2010 Pearson Education, Inc.
Factors Limiting Clot Growth or Formation • Two mechanisms limit clot size • Swift removal and dilution of clotting factors • Inhibition of activated clotting factors • Heparin in basophil and mast cells inhibits thrombin by enhancing antithrombin III Copyright © 2010 Pearson Education, Inc.
Factors Preventing Undesirable Clotting • Platelet adhesion is prevented by • Smooth endothelial lining of blood vessels • Antithrombic substances nitric oxide and prostacyclin secreted by endothelial cells • Vitamin E quinine, which acts as a potent anticoagulant Copyright © 2010 Pearson Education, Inc.
Disorders of Hemostasis • Thromboembolytic disorders: undesirable clot formation • Bleeding disorders: abnormalities that prevent normal clot formation Copyright © 2010 Pearson Education, Inc.
Thromboembolytic Conditions • Thrombus: clot that develops and persists in unbroken blood vessel • May block circulation leading to tissue death • Embolus: thrombus freely floating in blood • Embolism: embolus obstructing a vessel • E. g. , pulmonary and cerebral emboli • Risk factors – atherosclerosis, inflammation, slowly flowing blood or blood stasis from immobility Copyright © 2010 Pearson Education, Inc.
Thromboembolytic Conditions • Aspirin • Antiprostaglandin that inhibits thromboxane A 2 • Heparin • Anticoagulant used clinically • Warfarin (Coumadin) • Used for atrial fibrillation • Interferes with action of vit K • Dabigatran directly inhibits thrombin Copyright © 2010 Pearson Education, Inc.
Bleeding Disorders • Thrombocytopenia: deficient number of circulating platelets • Petechiae appear due to spontaneous, widespread hemorrhage • Due to suppression or destruction of bone marrow (e. g. , malignancy, radiation) • Platelet count <50, 000/mm 3 is diagnostic • Treated with transfusion of concentrated platelets Copyright © 2010 Pearson Education, Inc.
Petechiae (puh-TEE-kee-ee) are pinpoint, round spots that appear as a result of bleeding under the skin. The bleeding appear red, brown or purple. Petechiae may look like a rash. Usually flat to the touch, petechiae don't lose color (blanch) when you press on them. Copyright © 2010 Pearson Education, Inc.
Bleeding Disorders • Impaired liver function • Inability to synthesize procoagulants • Causes include vitamin K deficiency, hepatitis, and cirrhosis • Liver disease can also prevent the liver from producing bile, impairing fat and vitamin K absorption Copyright © 2010 Pearson Education, Inc.
Bleeding Disorders • Hemophilias include several similar hereditary bleeding disorders • Hemophilia A: most common type (77% of all cases); due to a deficiency of factor VIII • Hemophilia B: deficiency of factor IX • Hemophilia C: mild type; deficiency of factor XI • Symptoms include prolonged bleeding, especially into joint cavities • Treated with plasma transfusions and injection of missing factors Copyright © 2010 Pearson Education, Inc.
Human Blood Groups • RBC bear 30 types of glycoprotein antigens • Anything perceived as foreign; generates an immune response • Promoters of agglutination; called agglutinogens • Mismatched transfused blood perceived as foreign • May be agglutinated and destroyed; can be fatal • Presence or absence of each antigen is used to classify blood cells into different groups Copyright © 2010 Pearson Education, Inc.
Table 17. 4 ABO Blood Groups Copyright © 2010 Pearson Education, Inc.
Rh Blood Groups • There are 45 different Rh agglutinogens (Rh factors) • C, D, and E are most common • Rh+ indicates presence of D Copyright © 2010 Pearson Education, Inc.
Rh Blood Groups • Anti-Rh antibodies are not spontaneously formed in Rh– individuals • Anti-Rh antibodies form if an Rh– individual receives Rh+ blood • A second exposure to Rh+ blood will result in a typical transfusion reaction Copyright © 2010 Pearson Education, Inc.
Homeostatic Imbalance: Hemolytic Disease of the Newborn • Also called erythroblastosis fetalis • Rh– mother becomes sensitized when exposure to Rh+ blood causes her body to synthesize anti-Rh antibodies • Anti-Rh antibodies cross the placenta and destroy the RBCs of an Rh+ baby Copyright © 2010 Pearson Education, Inc.
Transfusion Reactions • Occur if mismatched blood is infused • Donor’s cells • Are attacked by the recipient’s plasma agglutinins • Agglutinate and clog small vessels • Rupture and release free hemoglobin into the bloodstream • Result in • Diminished oxygen-carrying capacity • Hemoglobin in kidney tubules and renal failure Copyright © 2010 Pearson Education, Inc.
ABO Blood Typing Copyright © 2010 Pearson Education, Inc.
Copyright © 2010 Pearson Education, Inc.
Blood being tested Type AB (contains agglutinogens A and B; agglutinates with both sera) Anti-A Serum Anti-B RBCs Type A (contains agglutinogen A; agglutinates with anti-A) Type B (contains agglutinogen B; agglutinates with anti-B) Type O (contains no agglutinogens; does not agglutinate with either serum) Copyright © 2010 Pearson Education, Inc. Figure 17. 16
Developmental Aspects • Fetal blood cells form in fetal yolk sac, liver, and spleen • Red bone marrow is primary hematopoietic area by seventh month • The fetus forms Hb. F, which has a higher affinity for O 2 than hemoglobin A formed after birth Copyright © 2010 Pearson Education, Inc.